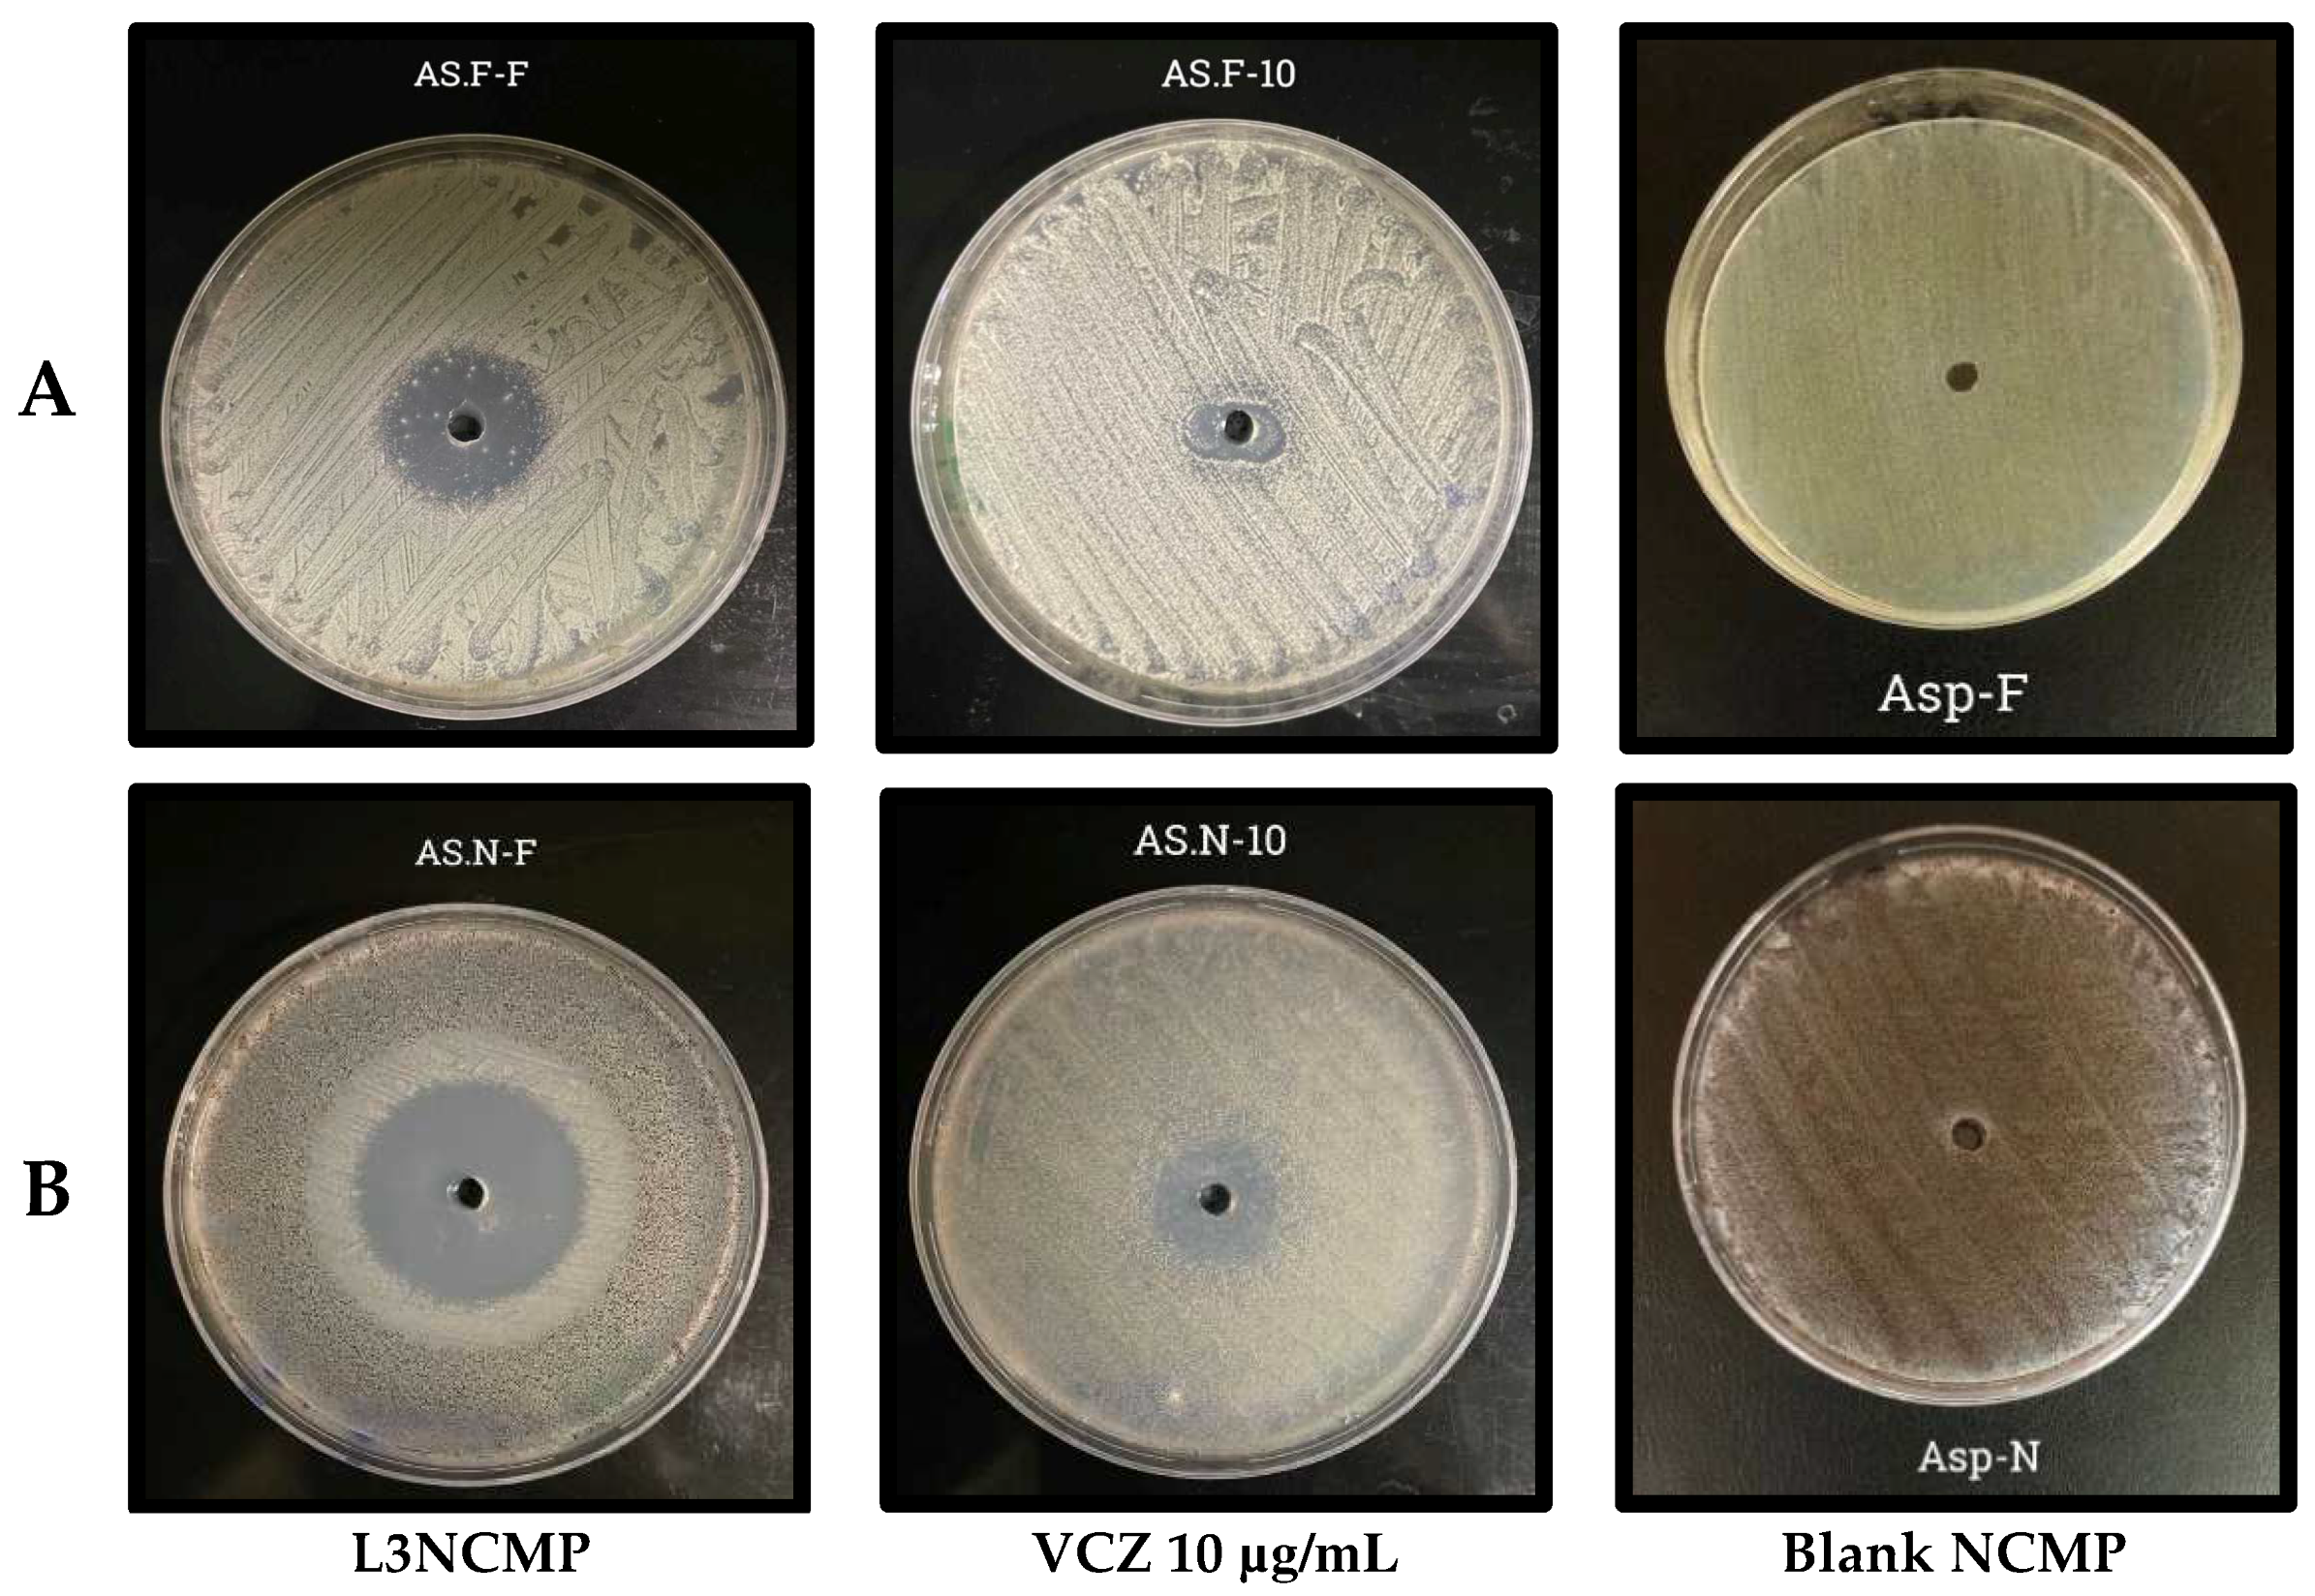
Pharmaceutics 16 00897 g007

A Novel Inhalable Dry Powder to Trigger Delivery of Voriconazole for Effective Management of Pulmonary Aspergillosis
Abstract
1. Introduction
2. Materials and Methods
2.1. Materials
2.2. Methods
2.2.1. Preparation of VCZ-Loaded Liposomes (VCZ-Ls)
2.2.2. Physicochemical Characterization of the VCZ-Ls
Particle Size, Polydispersity Index, and Zeta-Potential Measurements
Morphological Analysis
Encapsulation Efficiency
In Vitro Release Study
2.2.3. Preparation of Nanocomposite Microparticles (NCMPs)
2.2.4. Characterization of Nanocomposite Microparticles (NCMPs)
Spray-Dried Powder Yield (%)
Determination of the Drug Content of the Spray-Dried Powders
Size and Morphology of Spray-Dried Powders
Fourier Transform Infrared (FTIR) Spectroscopy
Cell Viability Study
Studies of Antifungal Activity
Stability Study
2.2.5. Statistical Data Analysis
3. Results
3.1. Physicochemical Characterization of VCZ-L Formulations
3.1.1. Particle Size, Polydispersity Index, and Zeta-Potential Measurements
3.1.2. Morphology of Liposomes
3.1.3. Encapsulation Efficiency %
3.1.4. In Vitro Release Study
3.2. Characterization of Nanocomposite Microparticles (NCMPs)
3.2.1. Production Yield %
3.2.2. Determination of the Drug Content of the Spray-Dried Powders
3.2.3. Scanning Electron Microscopy
3.2.4. Fourier Transform Infrared Spectroscopy
3.2.5. Cell Viability Study
3.2.6. Studies of Antifungal Activity
3.2.7. Stability Study
4. Discussion
5. Conclusions
Author Contributions
Funding
Institutional Review Board Statement
Informed Consent Statement
Data Availability Statement
Acknowledgments
Conflicts of Interest
References
- Carroll, K.C.; Adams, L.L. Lower Respiratory Tract Infections. Microbiol. Spectr. 2016, 4. [Google Scholar] [CrossRef]
- Pooni, P.A.; Chinna, D.; Kaushal, V.; Singh, D. Life threatening allergic bronchopulmonary aspergillosis (ABPA) in a previously well child due to acute exposure to pulse infested with Aspergillus flavus. Pediatr. Infect. Dis. 2014, 6, 15–17. [Google Scholar] [CrossRef]
- Husain, S.; Camargo, J.F. Invasive Aspergillosis in solid-organ transplant recipients: Guidelines from the American Society of Transplantation Infectious Diseases Community of Practice. Clin. Transplant. 2019, 33, e13544. [Google Scholar] [CrossRef] [PubMed]
- Cheng, S.N.; Tan, Z.G.; Pandey, M.; Srichana, T.; Pichika, M.R.; Gorain, B.; Choudhury, H. A Critical Review on Emerging Trends in Dry Powder Inhaler Formulation for the Treatment of Pulmonary Aspergillosis. Pharmaceutics 2020, 28, 1161. [Google Scholar] [CrossRef] [PubMed]
- Kim, S.H.; Yim, D.S.; Choi, S.M.; Kwon, J.C.; Han, S.; Lee, D.G.; Park, C.; Kwon, E.Y.; Park, S.H.; Choi, J.H.; et al. Voriconazole-related severe adverse events: Clinical application of therapeutic drug monitoring in Korean patients. Int. J. Infect. Dis. 2011, 15, e753–e758. [Google Scholar] [CrossRef]
- Castoldi, A.; Herr, C.; Niederstrasser, J.; Labouta, H.I.; Melero, A.; Gordon, S.; Schneider Daum, N.; Bals, R.; Lehr, C.M. Calcifediol-loaded liposomes for local treatment of pulmonary bacterial infections. Eur. J. Pharm. Biopharm. 2017, 118, 62–67. [Google Scholar] [CrossRef]
- Duan, X.P.; Li, Y.P. Physicochemical characteristics of nanoparticles affect circulation, biodistribution, cellular internalization, and trafficking. Small 2013, 9, 1521–1532. [Google Scholar] [CrossRef]
- Cooley, M.; Sarode, A.; Hoore, M.; Fedosov, D.A.; Mitragotri, S.; Gupta, A.S. Influence of particle size and shape on their margination and wall-adhesion: Implications in drug delivery vehicle design across nano-to-micro scale. Nanoscale 2018, 10, 15350–15364. [Google Scholar] [CrossRef] [PubMed]
- Nisini, R.; Poerio, N.; Mariotti, S.; De Santis, F.; Fraziano, M. The multiroleof liposomes in therapy and prevention of infectious diseases. Front. Immunol. 2018, 9, 155. [Google Scholar] [CrossRef]
- Nobbmann, U.L. Polydispersity—What Does It Mean for DLS and Chromatography. 2014. Available online: http://www.materials-talks.com/blog/2014/10/23/polydispersity-what-does-it-mean-for-dls-and-chromatography/ (accessed on 14 March 2018).
- Danaei, M.; Dehghankhold, M.; Ataei, S.; Hasanzadeh Davarani, F.; Javanmard, R.; Dokhani, A.; Khorasani, S.; Mozafari, M.R. Impact of Particle Size and Polydispersity Index on the Clinical Applications of Lipidic Nanocarrier Systems. Pharmaceutics 2018, 10, 57. [Google Scholar] [CrossRef]
- Chai, G.; Park, H.; Yu, S.; Zhou, F.; Li, J.; Xu, Q.; Zhou, Q.T. Evaluation of co-delivery of colistin and ciprofloxacin in liposomes using an in vitro human lung epithelial cell model. Int. J. Pharm. 2019, 569, 118616. [Google Scholar] [CrossRef] [PubMed]
- Veloso, D.F.; Benedetti, N.I.; Ávila, R.I.; Bastos, T.S.; Silva, T.C.; Silva, M.R.; Lima, E.M. Intravenous delivery of a liposomal formulation of voriconazole improves drug pharmacokinetics, tissue distribution, and enhances antifungal activity. Drug Deliv. 2018, 25, 1585–1594. [Google Scholar] [CrossRef] [PubMed]
- Chennakesavulu, S.; Mishra, A.; Sudheer, A.; Sowmya, C.; Suryaprakash Reddy, C.; Bhargav, E. Pulmonary delivery of liposomal dry powder inhaler formulation for effective treatment of idiopathic pulmonary fibrosis. Asian J. Pharm. Sci. 2018, 13, 91–100. [Google Scholar] [CrossRef] [PubMed]
- Hoo, L.S. Fungal fatal attraction: A mechanistic review on targeting liposomal amphotericin B (AmBisome®) to the fungal membrane. J. Liposome Res. 2017, 27, 180–185. [Google Scholar] [CrossRef] [PubMed]
- de Boer, A.H.; Hagedoorn, P.; Hoppentocht, M.; Buttini, F.; Grasmeijer, F.; Frijlink, H.W. Dry powder inhalation: Past, present and future. Expert Opin. Drug Deliv. 2017, 14, 499–512. [Google Scholar] [CrossRef] [PubMed]
- Ibrahim, M.; Verma, R.; Garcia-Contreras, L. Inhalation drug delivery devices: Technology update. Med. Devices (Auckl. NZ) 2015, 8, 131–139. [Google Scholar] [CrossRef]
- Gilbert, I.; Millette, L.A.; Riebe, M. Inhalation device options for the management of chronic obstructive pulmonary disease AU—DePietro, Michael. Postgrad. Med. 2018, 130, 83–97. [Google Scholar] [CrossRef]
- Geller, D.E. Comparing clinical features of the nebulizer, metered-dose inhaler, and dry powder inhaler. Respir. Care 2005, 50, 1313–1322. [Google Scholar]
- Claus, S.; Weiler, C.; Schiewe, J.; Friess, W. How can we bring high drug doses to the lung. Eur. J. Pharm. Biopharm. 2014, 86, 1–6. [Google Scholar] [CrossRef]
- Soliman, G.M. Nanoparticles as safe and effective delivery systems of antifungal agents: Achievements and challenges. Int. J. Pharm. 2017, 523, 15–32. [Google Scholar] [CrossRef]
- Bhuiyan, S.I.; Sayed, M.A.; Mustafiz, M.I.; Kabir, M.J.; Aktar, J. Metered dose inhaler (MDI) versus dry powder inhaler (DPI): Patient’s compliance variation in asthma medication at rural Bangladesh perspective. J. Dent. Med. Sci. 2018, 17, 66–75. [Google Scholar]
- Nelson, H.S. Inhalation devices, delivery systems, and patient technique. Ann. Allergy Asthma Immunol. 2016, 117, 606–612. [Google Scholar] [CrossRef] [PubMed]
- Gallo, L.; Bucalá, V. A review on influence of spray drying process parameters on the production of medicinal plant powders. Curr. Drug Discov. Technol. 2019, 16, 340–354. [Google Scholar] [CrossRef] [PubMed]
- Seville, P.C.; Li, H.Y.; Learoyd, T.P. Spray-dried powders for pulmonary drug delivery. Crit. Rev. Ther. Drug Carr. Syst. 2007, 24, 307–360. [Google Scholar] [CrossRef]
- Prime, D.; Atkins, P.J.; Slater, A.; Sumby, B. Review of dry powder inhalers. Adv. Drug Deliv. Rev. 1997, 26, 51–58. [Google Scholar] [CrossRef] [PubMed]
- Lin, D.; Li, G.; Chen, L. Determination of voriconazole in human plasma by hplc-esi-ms and application to pharmacokinetic study. J. Chromatogr. Sci. 2013, 51, 485–489. [Google Scholar] [CrossRef] [PubMed]
- Hamdan, A.M. Design, Formulation and Characterization of Liposomal Preparation of Voriconazole (VRC). 2015. Available online: www.jpbms.info (accessed on 3 April 2022).
- Almurshedi, A.S.; Aljunaidel, H.A.; Alquadeib, B.; Aldosari, B.N.; Alfagih, I.M.; Almarshidy, S.S.; Eltahir, E.K.D.; Mohamoud, A.Z. Development of inhalable nanostructured lipid carriers for ciprofloxacin for noncystic fibrosis bronchiectasis treatment. Int. J. Nanomed. 2021, 16, 2405–2417. [Google Scholar] [CrossRef] [PubMed]
- Zhang, Y.; Huo, M.; Zhou, J.; Zou, A.; Li, W.; Yao, C.; Xie, S. DDSolver: An add-in program for modeling and comparison of drug dissolution profiles. AAPS J. 2010, 12, 263–271. [Google Scholar] [CrossRef]
- Zhang, T.; Youan, B.-B.C. Analysis of Process Parameters Affecting Spray-Dried Oily Core Nanocapsules Using Factorial Design. AAPS PharmSciTech 2010, 11, 1422–1431. [Google Scholar] [CrossRef]
- Li, W.-R.; Shi, Q.-S.; Ouyang, Y.-S.; Chen, Y.-B.; Duan, S.-S. Antifungal effects of citronella oil against Aspergillus niger ATCC 16404. Appl. Microbiol. Biotechnol. 2013, 97, 7483–7492. [Google Scholar] [CrossRef]
- Fahr, A.; van Hoogevest, P.; May, S.; Bergstrand, N.; Leigh, M.L.S. Transfer of lipophilic drugs between liposomal membranes and biological interfaces: Consequences for drug delivery. Eur. J. Pharm. Sci. 2005, 26, 251–265. [Google Scholar] [CrossRef] [PubMed]
- Karanth, H.; Murthy, R.S.R. pH-Sensitive liposomes-principle and application in cancer therapy. J. Pharm. Pharmacol. 2010, 59, 469–483. [Google Scholar] [CrossRef]
- Michaelis, U.; Haas, H. Targeting of cationic liposomes to endothelial tissue. In Liposome Technology: Interactions of Liposomes with the Biological Milieu; Routledge: London, UK, 2006; pp. 151–170. [Google Scholar]
- Mayer, L.D.; Hope, M.J.; Cullis, P.R. Vesicles of variable sizes produced by a rapid extrusion procedure. Biochim. Biophys. Acta (BBA)-Biomembr. 1986, 858, 161–168. [Google Scholar] [CrossRef]
- Qi, X.-R.; Zhao, W.; Zhuang, S. Comparative study of the in vitro and in vivo characteristics of cationic and neutral liposomes. Int. J. Nanomed. 2011, 6, 3087–3098. [Google Scholar] [CrossRef] [PubMed]
- Nallamothu, R.; Wood, G.C.; Kiani, M.F.; Moore, B.M.; Horton, F.P.; Thoma, L.A. A targeted liposome delivery system for combretastatin A4: Formulation optimization through drug loading and in vitro release studies. PDA J. Pharm. Sci. Technol. 2006, 60, 144–155. [Google Scholar]
- Mangal, S.; Nie, H.; Xu, R.; Guo, R.; Cavallaro, A.; Zemlyanov, D.; Zhou, Q. Physico-Chemical Properties, Aerosolization and Dissolution of Co-Spray Dried Azithromycin Particles with L-Leucine for Inhalation. Pharm. Res. 2018, 35, 1–15. [Google Scholar] [CrossRef]
- Peppas, N.A.; Sahlin, J.J. A simple equation for the description of solute release. III. Coupling of diffusion and relaxation. Int. J. Pharm. 1989, 57, 169–172. [Google Scholar] [CrossRef]
- Uskokovic, D.; Stevanovic, M. Poly(lactide-co-glycolide)-based Micro and Nanoparticles for the Controlled Drug Delivery of Vitamins. Curr. Nanosci. 2009, 5, 1–14. [Google Scholar] [CrossRef]
- Taylor’, K.M.G.; Fan, S.J. Liposomes for drug delivery to the respiratory tract. Drug Dev. Ind. Pharm. 1993, 19, 123–142. [Google Scholar] [CrossRef]
- Sou, T.; Kaminskas, L.M.; Nguyen, T.H.; Carlberg, R.; McIntosh, M.P.; Morton, D.A.V. The effect of amino acid excipients on morphology and solid-state properties of multi-component spray-dried formulations for pulmonary delivery of biomacromolecules. Eur. J. Pharm. Biopharm. 2013, 83, 234–243. [Google Scholar] [CrossRef]
- Kunda, N.K.; Alfagih, I.M.; Dennison, S.R.; Tawfeek, H.M.; Somavarapu, S.; Hutcheon, G.A.; Saleem, I.Y. Bovine serum albumin adsorbed PGA-CO-PDL nanocarriers for vaccine delivery via dry powder inhalation. Pharm. Res. 2015, 32, 1341–1353. [Google Scholar] [CrossRef] [PubMed]
- Tawfeek, H.; Khidr, S.; Samy, E.; Ahmed, S.; Murphy, M.; Mohammed, A.; Shabir, A.; Hutcheon, G.; Saleem, I. Poly(glycerol adipate-co-Ω-pentadecalactone) Spray-dried microparticles as sustained release carriers for pulmonary delivery. Pharm. Res. 2011, 28, 2086–2097. [Google Scholar] [CrossRef] [PubMed]
- Patil, J.S.; Sarasija, S. Pulmonary drug delivery strategies: A concise, systematic review. Lung India 2012, 29, 44–49. [Google Scholar] [CrossRef] [PubMed]
- Khalef, L.; Lydia, R.; Filicia, K.; Moussa, B. Cell viability and cytotoxicity assays: Biochemical elements and cellular compartments. Cell Biochem. Funct. 2024, 42, e4007. [Google Scholar] [CrossRef]
- Tolman, J.A.; Nelson, N.A.; Son, Y.J.; Bosselmann, S.; Wiederhold, N.P.; Peters, J.I.; McConville, J.T.; Williams, R.O. Characterization and pharmacokinetic analysis of aerosolized aqueous voriconazole solution. Eur. J. Pharm. Biopharm. 2009, 72, 199–205. [Google Scholar] [CrossRef]
- Kaur, R.; Dennison, S.R.; Burrow, A.J.; Rudramurthy, S.M.; Swami, R.; Gorki, V.; Katare, O.P.; Kaushik, A.; Singh, B.; Singh, K.K. Nebulised surface-active hybrid nanoparticles of voriconazole for pulmonary Aspergillosis demonstrate clathrin-mediated cellular uptake, improved antifungal efficacy and lung retention. J. Nanobiotechnol. 2021, 19, 199–205. [Google Scholar] [CrossRef] [PubMed]
- Hashem, A.H.; Saied, E.; Amin, B.H.; Alotibi, F.O.; Al-Askar, A.A.; Arishi, A.A.; Elkady, F.M.; Elbahnasawy, M.A. Antifungal activity of biosynthesized silver nanoparticles (AgNPs) against aspergilli causing aspergillosis: Ultrastructure Study. J. Funct. Biomater. 2022, 13, 242. [Google Scholar] [CrossRef]
- Horvat, S.; Yu, Y.; Manz, H.; Keller, T.; Beilhack, A.; Groll, J.; Albrecht, K. Nanogels as Antifungal-Drug Delivery System against Aspergillus Fumigatus. Adv. NanoBiomed Res. 2021, 1, 2000060. [Google Scholar] [CrossRef]
- Slabbert, C.; Plessis, L.H.D.; Kotzé, A.F. Evaluation of the physical properties and stability of two lipid drug delivery systems containing mefloquine. Int. J. Pharm. 2011, 409, 209–215. [Google Scholar] [CrossRef]
- Grit, M.; Zuidam, N.J.; Underberg, W.J.M.; Crommelin, D.J.A. Hydrolysis of Partially Saturated Egg Phosphatidylcholine in Aqueous Liposome Dispersions and the Effect of Cholesterol Incorporation on Hydrolysis Kinetics. J. Pharm. Pharmacol. 1993, 45, 490–495. [Google Scholar] [CrossRef] [PubMed]
- Arora, S.; Haghi, M.; Young, P.M.; Kappl, M.; Traini, D.; Jain, S. Highly respirable dry powder inhalable formulation of voriconazole with enhanced pulmonary bioavailability. Expert Opin. Drug Deliv. 2016, 13, 183–193. [Google Scholar] [CrossRef] [PubMed]
- Fiegel, J.; Garcia-Contreras, L.; Thomas, M.; VerBerkmoes, J.; Elbert, K.; Hickey, A.; Edwards, D. Preparation and in vivo evaluation of a dry powder for inhalation of capreomycin. Pharm. Res. 2008, 25, 805–811. [Google Scholar] [CrossRef] [PubMed]
- Chan, J.G.Y.; Tyne, A.S.; Pang, A.; Chan, H.K.; Young, P.M.; Britton, W.J.; Duke, C.C.; Traini, D. A rifapentine-containing inhaled triple antibiotic formulation for rapid treatment of tubercular infection. Pharm. Res. 2014, 31, 1239–1253. [Google Scholar] [CrossRef] [PubMed]

| Formulations (VCZ/Lipid Ratio) | Mean Particle Size (nm) | PDI | Zeta Potential (mV) |
|---|---|---|---|
| F 1 (0.5:1) | 47.87 ± 1.47 | 0.123 | −19.4 ± 3.98 |
| F 2 (1:1) | 53.44 ± 0.79 | 0.117 | −23.4 ± 5.39 |
| F 3 (1.5:1) | 53.46 ± 0.93 | 0.116 | −26.0 ± 4.06 |
| Blank | 43.27 ± 1.62 | 0.125 | −2.74 ± 4.67 |
| Model/8 h | Parameter | F 1 | F 2 | F 3 |
|---|---|---|---|---|
| Zero-order | r2 | 0.6861 | 0.7334775 | 0.8315 |
| ko (h−1) | 5.360 | 7.592 | 10.495 | |
| First-order | r2 | 0.8099 | 0.8918 | 0.9604 |
| k1 (h−1) | 0.068 | 0.110 | 0.182 | |
| Higuchi | r2 | 0.9648 | 0.942858 | 0.9362 |
| k1 (h−½) | 13.094 | 18.462 | 25.256 | |
| Korsmeyer–Peppas | r2 | 0.9677 | 0.9519 | 0.9836 |
| kKP (h−n) | 12.369 | 16.587 | 20.526 | |
| “n” value | 0.536 | 0.567 | 0.629 | |
| Hixson–Crowell | r2 | 0.7728 | 0.8492 | 0.9548 |
| kHC | 0.21 | 0.32 | 0.51 |
| L1NCMPs | L2NCMPs | L3NCMPs | |
|---|---|---|---|
| Ratio (lipid/LEU) | 1:0.5 | 1:1 | 1:1.5 |
| Geometric particle size (µm) | 4.09 ± 0.19 | 3.74 ± 0.14 | 3.65 ± 0.73 |
| Production yield (%) | 66.80 ± 2.5 | 72.63 ± 4.13 | 80.41 ± 5.29 |
| Drug content % | 93.5 ± 3.9 | 90.7 ± 6.28 | 91.15 ± 4.7 |
| Fungal Strains | L3NCMPs (µg/mL) | Voriconazole (µg/mL) | |
|---|---|---|---|
| 2.5 | 10 | 25 | |
| Zone of Inhibition (mm) | |||
| Aspergillus flavus ATCC 9197 | 30 | 14 | 22 |
| Aspergillus niger ATCC 16404 | 40 | 20 | 26 |
| Time | Storage Condition (Temperature and Humidity) | Parameters | ||
|---|---|---|---|---|
| Particle Size (nm) | PDI | Drug Content (%) | ||
| Zero Time | 55 ± 3.46 | 0.145 ± 0.13 | 91.15 ± 4.7 | |
| After 1st month | 25 ± 2 °C/60 ± 5% RH | 53 ± 5.34 | 0.163 ± 0.12 | 90.95 ± 6.28 |
| 40 ± 2 °C/75 ± 5% RH | 58 ± 7.48 | 0.129 ± 0.12 | 90.42 ± 3.75 | |
| After 2nd month | 25 ± 2 °C/60 ± 5% RH | 60 ± 8.91 | 0.194 ± 0.15 | 91.15 ± 7.42 |
| 40 ± 2 °C/75 ± 5% RH | 67 ± 13.57 | 0.279 ± 0.17 | 89.74 ± 9.21 | |
| After 3rd month | 25 ± 2 °C/60 ± 5% RH | 86 ± 21.75 | 0.284 ± 0.21 | 83.15 ± 5.7 |
| 40 ± 2 °C/75 ± 5% RH | 105 ± 32.43 | 0.322 ± 0.24 | 72.86 ± 4.59 | |
Disclaimer/Publisher’s Note: The statements, opinions and data contained in all publications are solely those of the individual author(s) and contributor(s) and not of MDPI and/or the editor(s). MDPI and/or the editor(s) disclaim responsibility for any injury to people or property resulting from any ideas, methods, instructions or products referred to in the content. |
© 2024 by the authors. Licensee MDPI, Basel, Switzerland. This article is an open access article distributed under the terms and conditions of the Creative Commons Attribution (CC BY) license (https://creativecommons.org/licenses/by/4.0/).
Share and Cite
Almurshedi, A.S.; Almarshad, S.N.; Bukhari, S.I.; Aldosari, B.N.; Alhabardi, S.A.; Alkathiri, F.A.; Saleem, I.; Aldosar, N.S.; Zaki, R.M. A Novel Inhalable Dry Powder to Trigger Delivery of Voriconazole for Effective Management of Pulmonary Aspergillosis. Pharmaceutics 2024, 16, 897. https://doi.org/10.3390/pharmaceutics16070897
Almurshedi AS, Almarshad SN, Bukhari SI, Aldosari BN, Alhabardi SA, Alkathiri FA, Saleem I, Aldosar NS, Zaki RM. A Novel Inhalable Dry Powder to Trigger Delivery of Voriconazole for Effective Management of Pulmonary Aspergillosis. Pharmaceutics. 2024; 16(7):897. https://doi.org/10.3390/pharmaceutics16070897
Chicago/Turabian StyleAlmurshedi, Alanood S., Sarah N. Almarshad, Sarah I. Bukhari, Basmah N. Aldosari, Samiah A. Alhabardi, Fai A. Alkathiri, Imran Saleem, Noura S. Aldosar, and Randa Mohammed Zaki. 2024. "A Novel Inhalable Dry Powder to Trigger Delivery of Voriconazole for Effective Management of Pulmonary Aspergillosis" Pharmaceutics 16, no. 7: 897. https://doi.org/10.3390/pharmaceutics16070897
APA StyleAlmurshedi, A. S., Almarshad, S. N., Bukhari, S. I., Aldosari, B. N., Alhabardi, S. A., Alkathiri, F. A., Saleem, I., Aldosar, N. S., & Zaki, R. M. (2024). A Novel Inhalable Dry Powder to Trigger Delivery of Voriconazole for Effective Management of Pulmonary Aspergillosis. Pharmaceutics, 16(7), 897. https://doi.org/10.3390/pharmaceutics16070897

